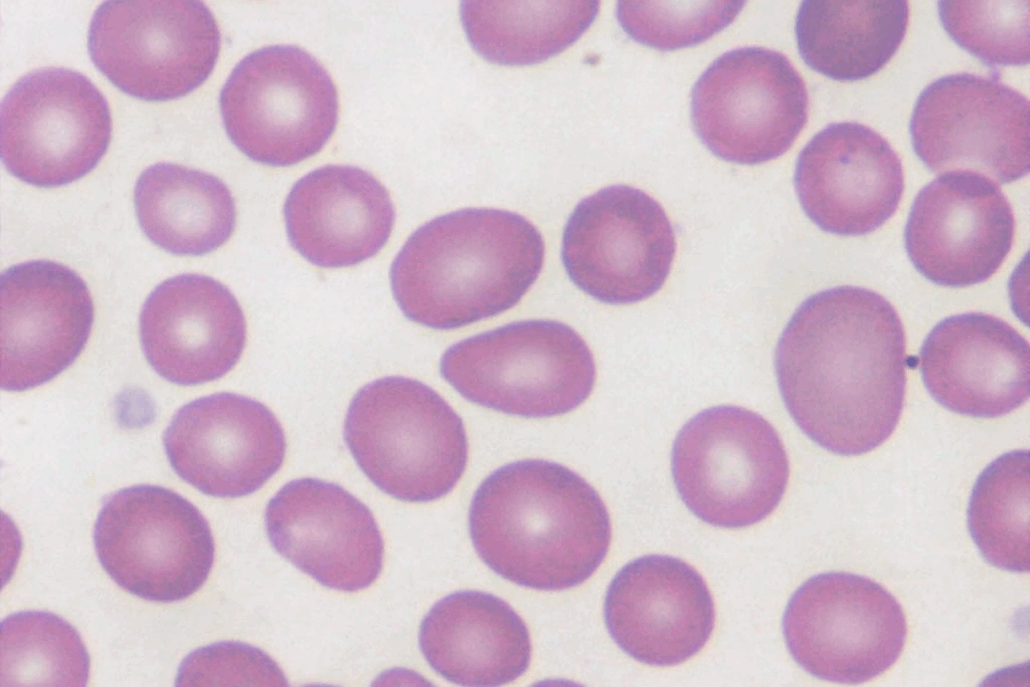

ALTERAÇÕES BIOQUÍMICAS NA ANEMIA MEGALOBLÁSTICA
A anemia megaloblástica é um tipo de anemia macrocítica caracterizada por alterações na síntese de DNA nos precursores eritroides, o que resulta em hemácias maiores e disfuncionais, tanto na medula óssea quanto na circulação periférica. Essa condição ocorre principalmente devido à deficiência de vitamina B12 e ácido fólico, nutrientes essenciais para a maturação celular, e pode ser causada por fatores como dieta inadequada, má absorção intestinal, gastrite atrófica crônica ou condições autoimunes, como a anemia perniciosa.

Fisiopatologia da Anemia Megaloblástica
Na anemia megaloblástica, a deficiência de vitamina B12 ou ácido fólico compromete vias bioquímicas essenciais para a síntese de DNA, resultando em replicação nuclear retardada enquanto a síntese de RNA e proteínas permanece relativamente preservada. Essa discrepância gera uma maturação nuclear assincrônica em relação ao citoplasma, levando à formação de precursores eritroides volumosos e imaturos na medula óssea, conhecidos como megaloblastos, bem como de hemácias circulantes aumentadas e ovaladas, denominadas macro-ovalócitos.

Associação da Anemia Megaloblástica com deficiência de B12 e ácido fólico
A vitamina B12 atua principalmente em duas formas: a metilcobalamina, que ajuda a converter a homocisteína em metionina e a regenerar o tetrahidrofolato para a produção de DNA, e a adenosilcobalamina, que participa do metabolismo de ácidos graxos e da formação de lipídios nos neurônios, o que explica as alterações neurológicas observadas na deficiência.
Por sua vez, os folatos, presentes como metiltetrahidrofolato nas células, também são essenciais para a síntese de DNA, uma vez que atuam como coenzimas em reações de transferência de grupos de carbono.
Quando há falta de B12 ou folato, a produção de glóbulos vermelhos fica prejudicada, pois o núcleo se desenvolve mais lentamente que o citoplasma. Dessa forma, surgem megaloblastos na medula óssea e macro-ovalócitos no sangue periférico, além de alterações como macrocitose, hipersegmentação de neutrófilos, anisocitose e poiquilocitose.
Além disso, a deficiência de B12 geralmente ocorre por má absorção intestinal, gastrite atrófica ou anemia perniciosa, enquanto que a falta de folato está ligada a dietas pobres, maior demanda ou má absorção. Por isso, identificar a causa exata é fundamental, já que o tratamento depende do diagnóstico correto.
Manifestações Clínicas
- Hematopoiéticas: anemia macrocítica, neutrófilos hipersegmentados, leucopenia e plaquetopenia.
- Epiteliais-mucosas: glossite, queilite, úlceras orais e gastrite atrófica; hiperpigmentação e baixa imunidade na deficiência de B12.
- Neurológicas: parestesias, déficit sensitivo, marcha atáxica e sinais de desmielinização, típicos da deficiência de B12.
- Gestação e desenvolvimento: atraso no crescimento e defeitos do tubo neural em deficiência de folato
Conclusão
A anemia megaloblástica, causada pela deficiência de vitamina B12 e ácido fólico, constitui um problema de saúde pública, caracterizando-se pela falha na maturação do material genético celular e pelo surgimento de anemia acentuada e pancitopenia. O diagnóstico precoce, por meio de hemograma e dosagens séricas de B12, ácido metilmalônico e homocisteína, é essencial para o início do tratamento adequado. Além disso, a conscientização sobre a importância de uma alimentação equilibrada é fundamental, pois a carência desses nutrientes pode gerar complicações irreversíveis.
Compreender a anemia megaloblástica vai muito além de identificar glóbulos vermelhos microcíticos. Saber relacionar essas alterações aos níveis de vitamina B12, ácido fólico, ácido metilmalônico e homocisteína é essencial para garantir diagnósticos precisos, antecipar complicações e oferecer maior segurança ao paciente.
Pós-Graduação em Bioquímica Clínica Avançada: Explore novos horizontes na sua carreira
Se você é um profissional dedicado na área da saúde em busca de aprimoramento e deseja desenvolver habilidades especializadas, senso crítico e expertise em Bioquímica Clínica, apresentamos a nossa Pós-Graduação como a escolha ideal para impulsionar sua carreira.
Desenvolvido para capacitar e atualizar profissionais como você, nosso programa altamente especializado oferece conhecimentos avançados que não apenas enriquecerão sua base de habilidades, mas também o destacarão no competitivo cenário profissional.
Oferecemos uma opção conveniente para quem busca uma pós-graduação 100% online e ao vivo, sem comprometer a excelência no ensino.
Nossa metodologia integra teoria e prática da rotina laboratorial, assegurando um aprendizado efetivo e aplicável.
Contamos com um corpo docente altamente qualificado, composto pelos melhores professores do Brasil, verdadeiras referências em suas respectivas áreas de atuação.
No Instituto Nacional de Medicina Laboratorial, nosso compromisso é singular: mais do que apenas transmitir conhecimento, buscamos transformar VOCÊ em uma referência.
Toque no botão abaixo e descubra mais sobre a Pós-Graduação em Bioquímica Clínica Avançada.
Sua jornada de excelência começa aqui.
QUERO CONHECER TODOS OS DETALHES DA PÓS-GRADUAÇÃO
Referências
MONTEIRO, Mirella Dias; FERREIRA, Nívia da Fonseca; MARINS, Fernanda Ribeiro; ASSIS, Isabela Bacelar de. Anemia megaloblástica: revisão de literatura. Revista Saúde em Foco, edição nº 11, p. 934, 2019.
POLETTO, Erica Regina. Anemia megaloblástica. Pós-Graduação Lato Sensu, nível de Especialização em Hematologia Clínica e Laboratorial. Orientador: Prof. Dr. Paulo Cesar Naoum. Disponível em: quinhapoletto@hotmail.com. Acesso em: 23 de novembro de 2025
PAZA, Raquel de; CANALES, Miguel A.; HERNÁNDEZ-NAVARRO, Fernando. Anemia megaloblástica: diagnóstico e tratamento. Medicina Clínica (Barcelona), v. 127, n. 5, p. 185-188, 2006. Serviço de Hematologia e Hemoterapia, Hospital Universitário La Paz; Universidade Autónoma de Madrid, Espanha.



